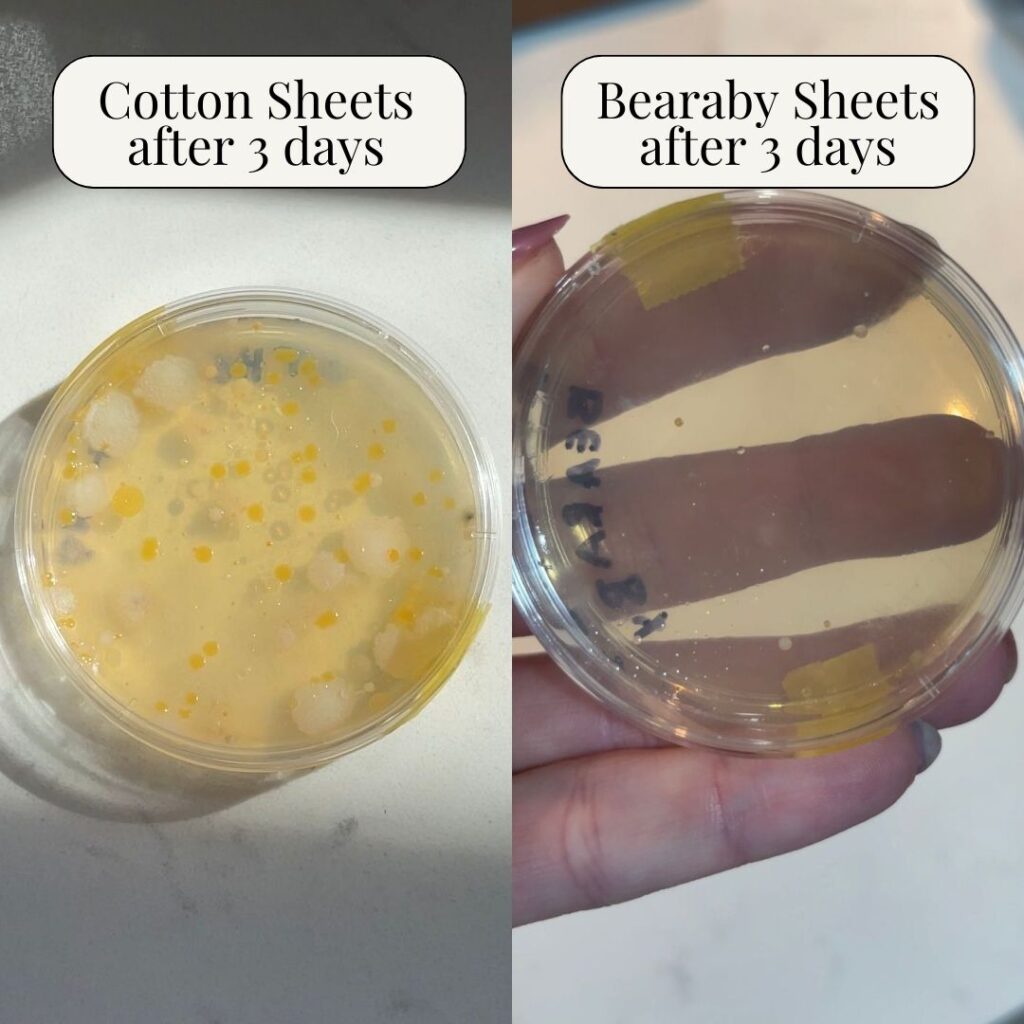

In One Week, Our Bedsheets Accumulate Up to 17,000x More Bacteria Than a Toilet Seat.
Let’s all just take a moment of silence for this one. I don’t know about you, but I consider my bed to be the ultimate safe haven, the place where I can finally de-stress and decompress after a long day. I didn’t realize it was also a safe haven for bacteria.
I kept seeing ads for these “anti-microbial,” Second Skin sheets from Bearaby… and I decided to do something a little crazy: run an experiment with a petri dish and see if the 17,000x more bacteria claim was legit or just another marketing scheme. I guess curiosity (and maybe a little masochism) got the best of me.
I ordered a set of these bamboo sheets infused with antimicrobial botanicals from Bearaby to see if they could fare any better than my standard cotton sheets. What I found was sort of atrocious. Within 48 hours, my “normal” sheet dish was a horror show of bacteria colonies… and the Bearaby dish was practically pristine.
Then I realized: it’s not about how often you wash your sheets, it’s about what they’re made of. I guess the “anti-microbial” claim wasn’t BS after all.
Take It From Me, Your Sheets Might Be Dirtier Than You Think.
Seeing the bacteria-infested petri dish scared me into hours of research. Apparently, we shed 500 million skin cells every day. Add in sweat, oils, pet dander, and a few hours of tossing and turning, and your bed becomes a five-star hotel for bacteria.
Even if you wash weekly (which, let’s be honest, few of us do), your sheets are never truly “clean.” The fibers trap moisture and dead skin, creating a perfect breeding ground for germs. That lingering musty smell isn’t just because the sheets are “stale.” It’s microbial life.

(Maybe you can now start to understand why I’ll never switch back to regular cotton sheets.)
Enter Bearaby’s Second Skin Sheets
I’d known about Bearby’s iconic weighted blankets for a while. My sister has one and obsesses over it. So, when I saw they launched these antimicrobial bamboo sheets, I was intrigued and also felt confident in the brand itself.
And I’m glad I took the chance, because now I won’t sleep on anything else. These aren’t your average “eco-friendly” linens. They’re “clinically clean,” which means they eliminate 99.9% of bacteria naturally. They’re also ISO 20743 certified (which is an international standard for determining antibacterial activity for textiles. Don’t worry, I hadn’t heard of it either.) Here’s what makes them special:
- Smart Botanicals: Infused with peppermint, mint, and marine proteins that fight bacteria without chemicals.
- 100% Bamboo Fibers: Breathable and temperature-regulating for a cool, sweat-free sleep.
- Soothing on Skin: Dermatologist-approved for eczema- and acne-prone sleepers.
- Hypoallergenic: Naturally reduces allergens, dust mites, and pet-borne irritants.
- Self-Cleaning Power: Keeps working even after dozens of washes.

Basically, they’re sheets that clean themselves. (I hope this goes without saying, but you should still wash them regularly.)
These Sheets Aren’t Just Clean, They’re Cozy, Too
I’m not sure what I expected “anti-microbial” sheets to feel like, but I can tell you I definitely didn’t expect them to be this buttery-soft and comfortable. The material feels like the smooth side of a silk pillowcase, but even cooler to the touch.
There’s no synthetic scent, no “coating” feel, just pure, breathable fabric. And here’s the thing: the “freshness” feeling doesn’t fade. Each time I slip into these sheets, they feel so smooth and refreshing.

And maybe it’s just the placebo effect, but frankly, I don’t care: Since I switched sheets, I’ve had clearer skin and fewer sniffles. If I consider the fact that I was sleeping in what I found in that cotton-sheet petri dish, it all makes sense, to be fair. Yet another reason why I will not be switching from Bearaby’s Second Skin anytime soon.
The Final Verdict: Bearaby’s Anti-Microbial Sheets Are More Than a Luxury, They’re a Necessity
After my week-long experiment, I couldn’t unsee those petri dishes. The visual difference between my regular sheets and Bearaby’s was astounding.
Now, my bed doesn’t just look clean, it is clean. No more bacterial buildup, no more musty mornings, no more skin breakouts from my pillowcase. Just the peace of mind from slipping into a bed that keeps me safe and comfortable. My guess is, if you could see what’s living in your sheets right now, you’d change them, too.
